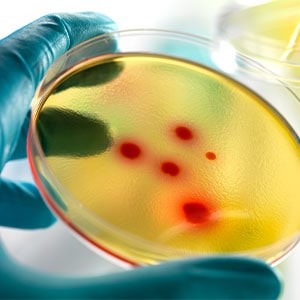

Filling Line Contamination can be generally avoided through an effective contamination monitoring system, starting with a risk assessment.
It is essential for a monitoring program to meet current regulations and good manufacturing practices for stable operation. Emerging practices should also be understood and planned for when verifying the performance of the final monitoring plan.
A theoretical case study involving the steps of classification, risk assessment and monitoring plan verification was conducted. The classification used total particle concentration and environmental monitoring data and established routine microbiological and particle monitoring points for an aseptic filling line. The cleanroom utilized Grade A, B, C and D zones.
After classification, a risk assessment of the defined monitoring points was performed. The points’ number and criticality were assigned using risk assessment methodologies such as FMEA, and the monitoring frequencies for individual locations were then calculated.
Routine Monitoring
The QRM approach, according to ICH Annex 20 “Quality Risk Management” and ICH Q9 “Guideline on Quality Risk Management”, is applied in order to perform a Risk Assessment, Risk Control, Risk Communication, and Risk Review.

Learn more… Complete the form to download the full paper.